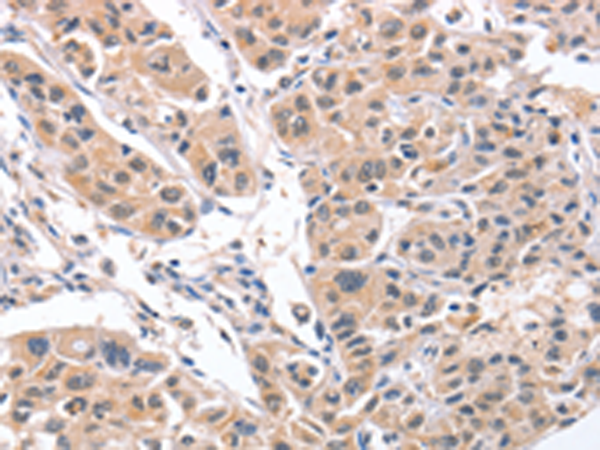

别名:AIM; API6; PRO229; Spalpha; SP-ALPHA应用:IHC
反应种属:Human, Mouse
规格:50μl/100μl
| Description |
|---|
| CD5L (CD5 molecule-like), also known as API6, PRO229, Spalpha or SP-ALPHA, is a 347 amino acid secreted protein that belongs to the scavenger receptor cysteine-rich (SRCR) family of leukocyte regulating proteins. Expressed in bone marrow, spleen, thymus, lymph node and fetal liver, CD5L is thought to be involved in regulating the immune system via binding to peripheral monocytes and mediating their activation and overall survival. CD5L has three cysteine-rich domains and, in addition to its role in the immune system, may function to inhibit apoptosis and promote macrophage survival. |
| Specification | |
|---|---|
| Aliases | AIM; API6; PRO229; Spalpha; SP-ALPHA |
| Swissprot | O43866 |
| Host/Isotype | Rabbit IgG |
| Storage | Store at 4°C short term. Aliquot and store at -20°C long term. Avoid freeze/thaw cycles. |
| Species Reactivity | Human, Mouse |
| Immunogen | Synthetic peptide of human CD5L |
| Formulation | pH7.4 PBS, 0.05% NaN3, 40% Glycerol |
| Application | |
|---|---|
| IHC | 1/25-1/100 |
| ELISA | 1/1000-1/5000 |
![]() |
The image is immunohistochemistry of paraffin-embedded Human liver cancer tissue using P04760(CD5L Antibody) at dilution 1/30. (Original magnification: ×200) |
![]() |
The image is immunohistochemistry of paraffin-embedded Human lung cancer tissue using P04760(CD5L Antibody) at dilution 1/30. (Original magnification: ×200) |
本公司的所有产品仅用于科学研究或者工业应用等非医疗目的,不可用于人类或动物的临床诊断或治疗,非药用,非食用。
暂无评论
本公司的所有产品仅用于科学研究或者工业应用等非医疗目的,不可用于人类或动物的临床诊断或治疗,非药用,非食用。
中文

发表回复